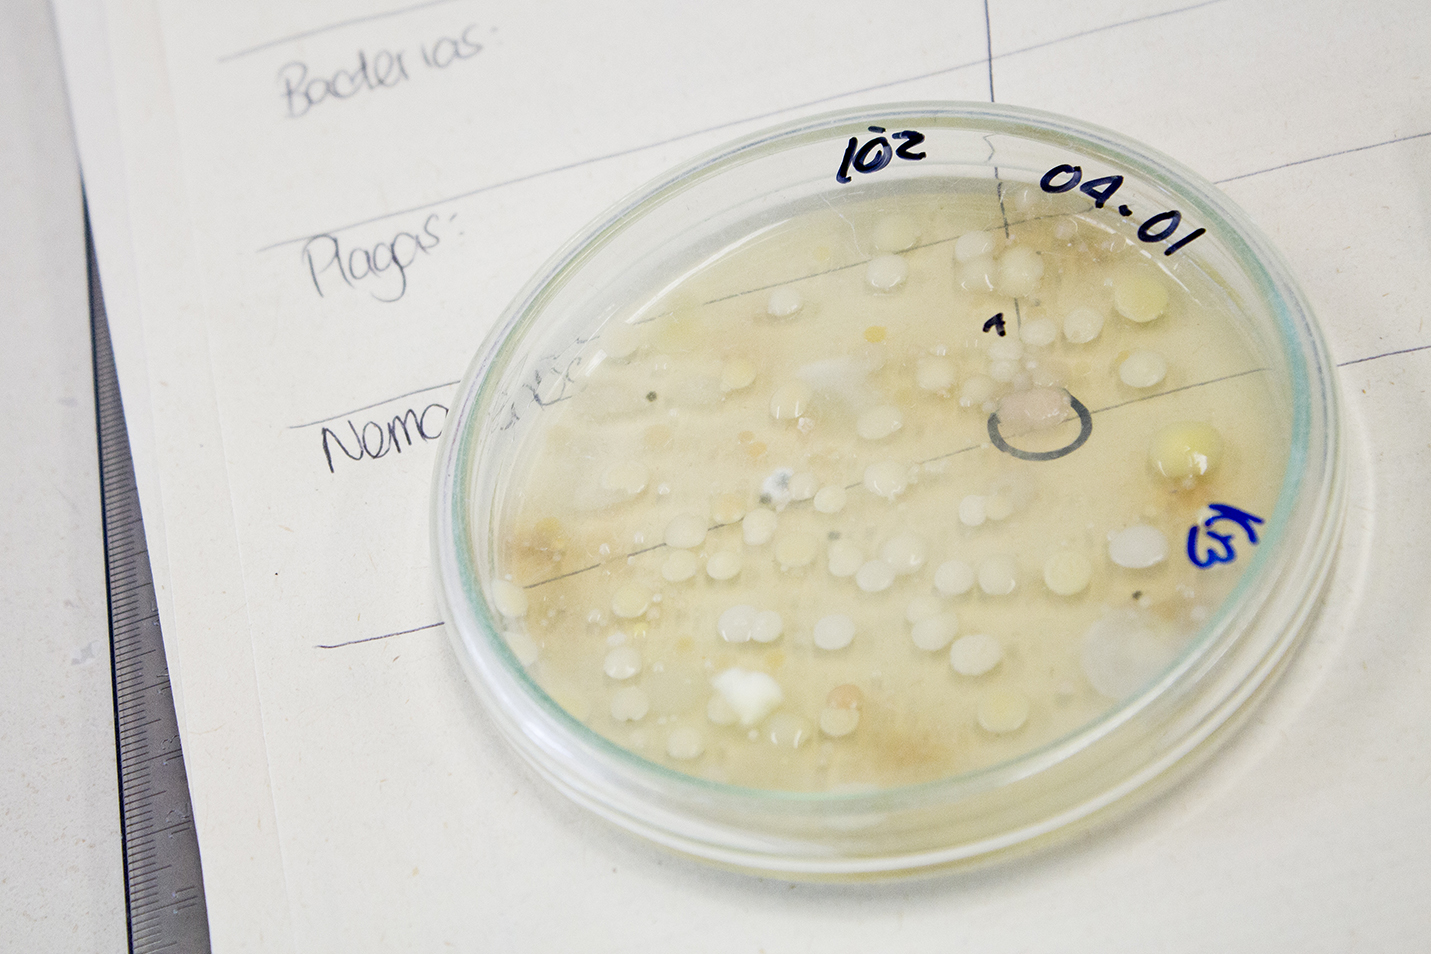

Centro de Bio-Sistemas de Utadeo continúa apoyando al sector agrícola con reapertura de sus laboratorios
Garantizar la seguridad alimentaria del país resulta de vital importancia en medio del aislamiento obligatorio decretado por el Gobierno nacional por cuenta de la emergencia sanitaria causada por el coronavirus. Uno de los sectores productivos vitales en esta tarea es el de los agricultores. Apoyando estos esfuerzos se encuentra el Centro de Bio-Sistemas de Utadeo que, desde el inicio de esta contingencia, se ha convertido no solo en la despensa en productos agrícolas de la más alta calidad para los ciudadanos que habitan Chía y sus alrededores, sino también para los productores, a través del suministro de plántulas para que continúen con sus ciclos de siembra.
Laboratorio de Inocuidad
Ahora, desde el pasado lunes 20 de abril, el Centro de Bio-Sistemas abrió nuevamente las puertas de sus cuatro laboratorios de análisis de muestras agrícolas, para que las empresas del sector continúen con sus cadenas productivas y de innovación, manteniendo así la rigurosidad de los resultados y los altos estándares de calidad de los productos que estas ofertan.
Como lo sostiene Luz Stella Fuentes, directora de este centro, los principales beneficiarios no son solo los productores agrícolas de Chía y municipios cercanos, sino que también lo son los que pertenecen a diferentes departamentos del país, pues ellos pueden enviar sus muestras a través de cualquier empresa transportadora, reciben los resultados por correo electrónico o por correspondencia, y pueden realizar el pago de los análisis por transferencia bancaria.
Seguimiento a la calidad de los bioinsumos
Fuentes también destacó que la apertura de los laboratorios se da bajo las más exigentes medidas de bioseguridad, entre ellas el ingreso de los clientes por turnos, se lleva a cabo de manera individual hasta un máximo de cinco personas; ademas, está el uso de gel antibacterial y solución alcohólica disponible en el ingreso a las instalaciones.
“Los resultados que les entregamos son una herramienta importante para la toma de decisiones en torno a su cultivo, desde el punto de vista de agua, suelos, residuos de plaguicidas, de metales pesados y manejo fitosanitario”, resalta Fuentes.
Análisis en Laboratorio de Suelos
Conoce los laboratorios del Centro de Bio-Sistemas:
Inocuidad Química: En este laboratorio se desarrollan análisis de residuos de plaguicidas en alimentos de origen vegetal y en suelos; análisis de residuos de medicamentos veterinarios en la leche, así como también de residuos de metales pesados en frutas y hortalizas. A partir de los resultados, se pueden tomar medidas que garanticen productos libres de compuestos químicos que puedan afectar la salud humana.
Suelos y aguas: Allí se llevan a cabo estudios físicoquímicos relacionados con los nutrientes presentes en los suelos y en materiales orgánicos, los cuales son indispensables para iniciar o corregir cultivos, pues de ellos depende el rendimiento en la producción agrícola. También se llevan a cabo el análisis químico de agua y de soluciones nutritivas para cultivos bajo invernadero, con el propósito de identificar si este líquido vital es apto para el riego. Finalmente, a través de análisis foliares, se identifican los nutrientes presentes en las plantas y permite establecer alguna deficiencia o toxicidad de los nutrientes esenciales para el adecuado desarrollo de esta.
Laboratorio de suelos y aguas
Microbiología agrícola y ambiental: A partir de muestras vegetales, se identifican patógenos, entre ellos virus, bacterias u hongos, que pueden estar afectando a los cultivos. De esta forma, se determina un manejo adecuado y se toman medidas fitosanitarias. También se ofrece el análisis de nematodos, es decir, de microorganismos y organismos patógenos que se encuentran en suelos, los cuales desencadenan enfermedades o plagas en las siembras. Finalmente, se desarrollan análisis de microorganismos benéficos para las plantas, entre ellos enemigos naturales de plagas.
Muestra en Laboratorio de Microbiologia Agrícola y Ambiental
Entomología: Se realiza control de calidad a bioinsumos de uso agrícola, así como el análisis de insumos biológicos, desarrollados a partir de organismos vivos como parasitoides o ácaros, agentes de vital importancia para el biocontrol de plagas. Los resultados del control son entregados al cliente y al ICA, pues este laboratorio se encuentra registrado ante dicha entidad.